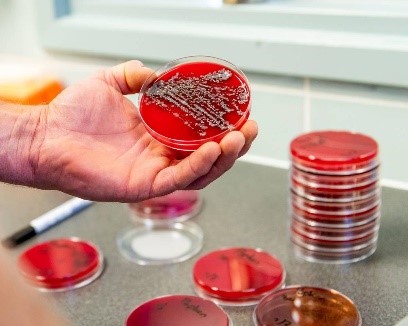

Uiergezondheid is één van de drie hoofdoorzaken voor de afvoer van koeien op een bedrijf. De basis van onze aanpak is het management omtrent uiergezondheid aan te pakken en zo samen met u, te werken aan gezonde koeien. Hiervoor hebben we verschillende speerpunten:
Opvolging celgetal door middel van Keno M
We doen aan bedrijfsspecifieke opvolging van celgetal op maat, met het programma Keno M. Hiermee kunnen we (op basis van de
MPR) iedere maand:
- alle belangrijke mastitis parameters precies berekenen
- voor elke individuele koe met een verhoogd celgetal een wetenschappelijk onderbouwd en economisch verantwoord advies uitbrengen
- in één oogopslag de zwaktes en sterktes in het uiergezondheidsmanagement zien
- een gepersonaliseerd, volledig en overzichtelijk verslag genereren
Bedrijven die al aan het programma meedoen, bemonsteren en behandelen iedere 4-6 weken een selectie van de koeien met een hoog celgetal. Hierdoor hebben deze bedrijven een veel betere controle over het tankmelkcelgetal en een beter inzicht in wat er aan de hand is op hun bedrijf.
Melk onderzoek
Aansluitend blijft natuurlijk ook de soort bacterie binnen het hele uiergezondheidsgamma van belang en kunt u nog altijd terecht in ons laboratorium voor bacteriologie. Na 24 uur bellen we u met tussentijdse uitslag van de koe met het verkeerde kwartier. Na 48 uur kunnen we eventueel nog bijsturen als de gevoeligheid van de gevonden bacterie anders blijkt te zijn dan de behandeling die is ingezet. In ons management programma houden we alles voor u bij. Op jaarbasis hebben we dan natuurlijk een mooi jaaroverzicht die we samen met u kunnen bespreken.
Natte melkmeeting
Aansluitend zijn we dit jaar ook begonnen met het uitvoeren van natte melk metingen. Met een dynamische meting van de melkinstallatie kunnen wij de bruikbaarheid van de installatie voor de aanwezige koeien onderzoeken. Deze metingen zijn vooral gericht op het vacuümverloop op verschillende plaatsen in de melkinstallatie. We maken hiervoor gebruik van de nieuwe Vadia meet apparatuur.
Hoe gaan we te werk?
Voor aanvang van het melken worden de Vadia sensoren gemonteerd op enkele melkstellen. De Vadia sensor werkt op een batterij en is klein en licht zodat hij aan de tepelbeker bevestigd kan worden tijdens het melken. De Vadia werkt volledig zelfstandig, waardoor wij geen aandacht aan de meting hoeven te geven, maar we ons volledig kunnen concentreren op de melkroutines. De geregistreerde data over werking van de melkmachine (o.a. vacuüm onder de stootrand, melkstroom) worden na de melking in detail ge
analyseerd met speciaal ontwikkelde analysesoftware. Op deze manier worden alle koeien die gemeten zijn met de sensor geïnventariseerd en kunnen wij in een samenvattend rapport het bedrijfsadvies op maat voor u klaarmaken. Vervolgens bespreken we in een vervolgbezoek alle resultaten in detail en krijgt u concrete adviezen die niet alleen betrekking hebben op de melkmachine en melktechniek, maar die ook het hele bedrijfsmanagement in verband met uiergezondheid kunnen betreffen.
Stalrondgang en weerstand van de koeien
Samen met u gaan we de koeien en hun omgeving bekijken. Gezonde koeien hebben een betere weerstand dus zeker de voeding en de mineralen status mogen niet ontbreken.
Droogzetten
Binnen de aanpak van tankmelkcelgetal en klinische mastitis besteden we zeker ook veel aandacht aan het droogzetten van koeien en het hele management er om heen. Samen met de veehouder doorlopen we de 10 stappen tot succesvol droogzetten. Benieuwd welke stappen dit zijn? Klik dan hier.
Vaccineren
Naast adviezen en ondersteuning in management van uiergezondheid, melktechniek en de natte melk meeting van de melkmachine, kunnen we u ook ondersteunen in behandeling en preventie met onder andere vaccinatie. Er bestaan 2 vaccins: Startvac© voor problemen met E. coli en S. aureus en sinds kort ook UBAC© voor problemen met Streptococcus uberis.